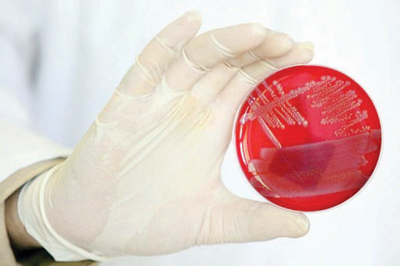

وصل عدد الوفيات في أوروبا من جراء الإصابة ببكتيريا أي-كولاي إلى 22 بينهم 21 في ألمانيا بحسب الأرقام الأخيرة التي نشرها أمس المركز الأوروبي لمراقبة الأمراض والوقاية منها في ستوكهولم.
وأضاف المصدر نفسه: إن 1605 إصابات أي-كولاي سجلت في دول الاتحاد الأوروبي و658 أي-كولاي مسببة للنزف المعوي.
ومعظم الحالات سجلت في ألمانيا بؤرة تفشي البكتيريا مع 1536 إصابة أي-كولاي و627 أي-كولاي مسببة للنزف المعوي.
وبالنسبة إلى حصيلة أمس الأول أحصى المركز 328 إصابة أي-كولاي جديدة و107 أي-كولاي مسببة للنزف المعوي.
وألمانيا هي الدولة التي أحصي فيها العدد الأكبر من الإصابات الجديدة خلال 24 ساعة.
لكن المركز أحصى أربع حالات جديدة في بريطانيا والدنمارك. وبحسب المعهد السويدي لمراقبة الأمراض المعدية فإن السويد سجلت أمس إصابة جديدة بهذه البكتيريا ما يرفع عدد الإصابات إلى 47 في هذا البلد. ومصدر البكتيريا لا يزال مجهولا، لكن منظمة الصحة العالمية قالت إن أي-كولاي نسخة من "0104:إتش4"، هي نسخة معروفة، لكنها المرة الأولى التي تتسبب في تفشي وباء.